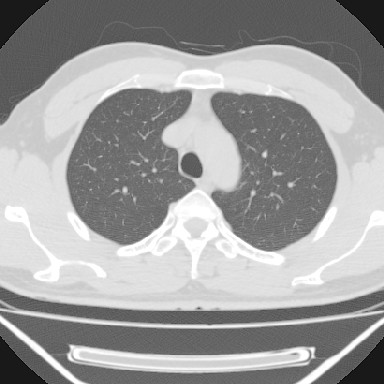
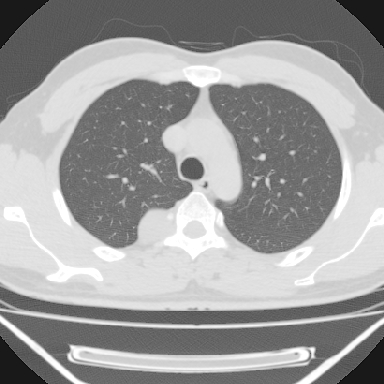
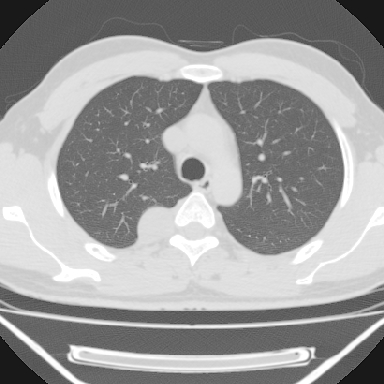
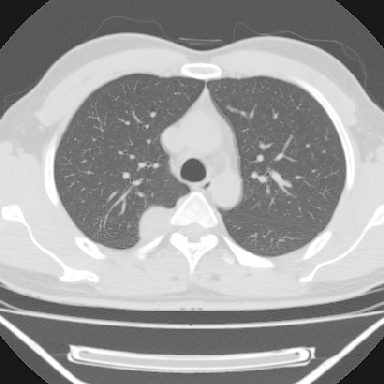
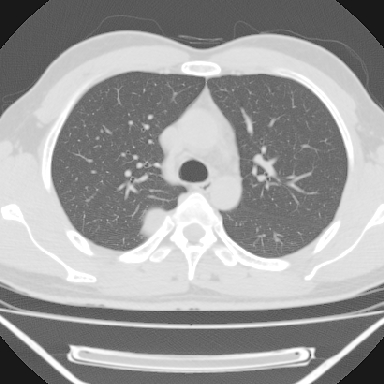
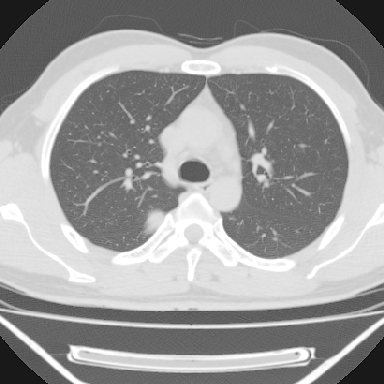
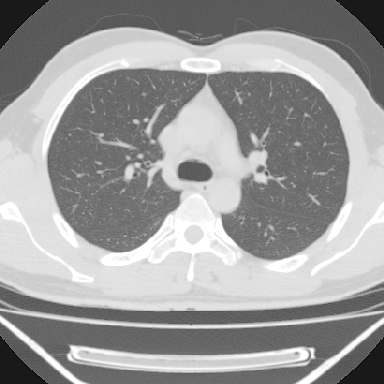
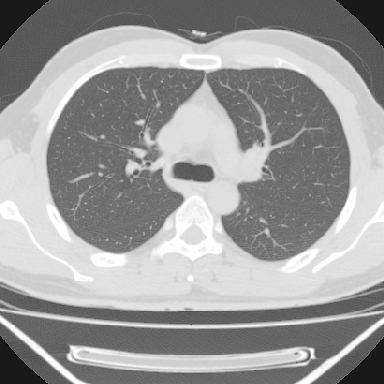

以下是引用余辉在2007-1-26 10:55:00的发言:[br][br]病灶与椎间孔间存在脂间隙,病灶较大,椎间无明显异常改变,与胸膜移行处可见尾状影,考虑胸膜肿瘤,以良性间皮瘤可能性大

以下是引用卜一在2007-1-26 10:45:00的发言:[br]支持:神经源性肿瘤.
以下是引用余辉在2007-1-26 10:55:00的发言:[br][br]病灶与椎间孔间存在脂间隙,病灶较大,椎间无明显异常改变,与胸膜移行处可见尾状影,考虑胸膜肿瘤,以良性间皮瘤可能性大

| 欢迎光临 医影在线 (http://bbs.radida.com/bbs/) | Powered by Discuz! X3.2 |